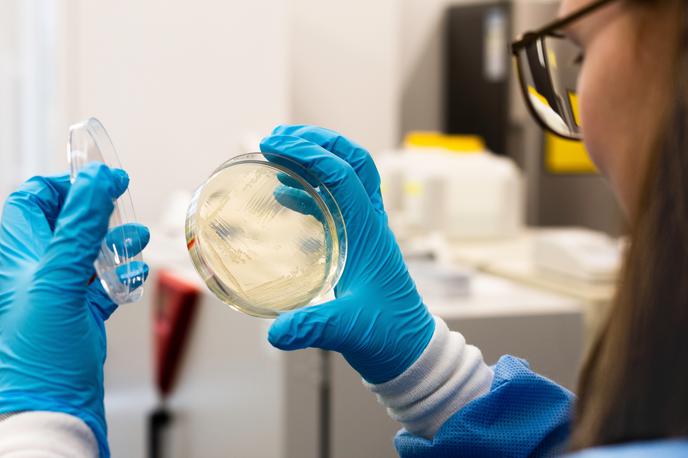
laboratorij, bakterije | Foto Shutterstock

Sreda, 26. 11. 2025, 21.27
37 minut
Zdravniki svarijo pred glivično okužbo: odporna je na zdravila in hitro se širi
Britanski dermatologi in mikrologi so zaskrbljeni zaradi hitrega širjenja glivične okužbe, ki je do pred nekaj let nazaj v Evropi skoraj nismo poznali. Gre za Trichophyton indotineae oziroma tako imenovano "superglivo", ki povzroča velike izpuščaje na koži in je odporna na večino standardnih zdravil, ki se uporabljajo za zdravljenje glivičnih okužb.
Glivo Trichophyton indotineae so prvič odkrili leta 2014 v Indiji, kjer je zdaj v nekaterih delih države razširjena na ravni epidemije. Od takrat se je prek mednarodnih potovanj razširila tudi na Bližnji vzhod, v Evropo in Severno Ameriko. Leta 2021 so prve primere okužbe zabeležili v Franciji in Nemčiji, leta 2023 pa tudi čez lužo v New Yorku. Glede na zadnje podatke je ena najbolj prizadetih držav v Evropi Velika Britanija.
"V Veliki Britaniji postaja resnično velik problem. Ne vemo, ali bo postala endemična ali celo pandemična bolezen, vendar je porast novih primerov v bolnišnicah izjemno skrb vzbujajoč," je za Mirror povedal Darius Armstrong-James, eden vodilnih britanskih strokovnjakov za glivične okužbe z londonskega Imperial Collegea.
Medtem ko je bila okužba s "superglivo" do leta 2021 v Veliki Britaniji izredno redka, se je število potrjenih primerov v zadnjem času hitro povečalo. Okužba se prenaša z neposrednim stikom s kožo, lahko pa tudi z dotikanjem okuženih površin v telovadnici, na bazenu in celo v frizerskih salonih.
Zahtevno in dolgotrajno zdravljenje
Izpuščaji se pojavijo predvsem v dimljah, na zadnjici in stegnih. Ker je "supergliva" odporna na zdravila, ki se običajno uporabljajo za zdravljenje glivičnih okužb, je v tem primeru zdravljenje precej zahtevno in dolgotrajno.
Trichophyton indotineae is a concerning emerging fungal infection.
— Neil Stone (@DrNeilStone) January 9, 2025
It causes a type of ringworm (a misnomer-its fungal!)
Its spreading globally and is VERY drug resistant
Its named for the fact it was first detected in India- tho we should stop naming pathogens after places! pic.twitter.com/jfOijr3OYv
Še posebej skrb vzbujajoče je, da kar 74 odstotkov pacientov v zadnjem času ni potovalo na ogrožena območja, kjer je "supergliva" razširjena, kar pomeni, da se gliva že prenaša lokalno.



















